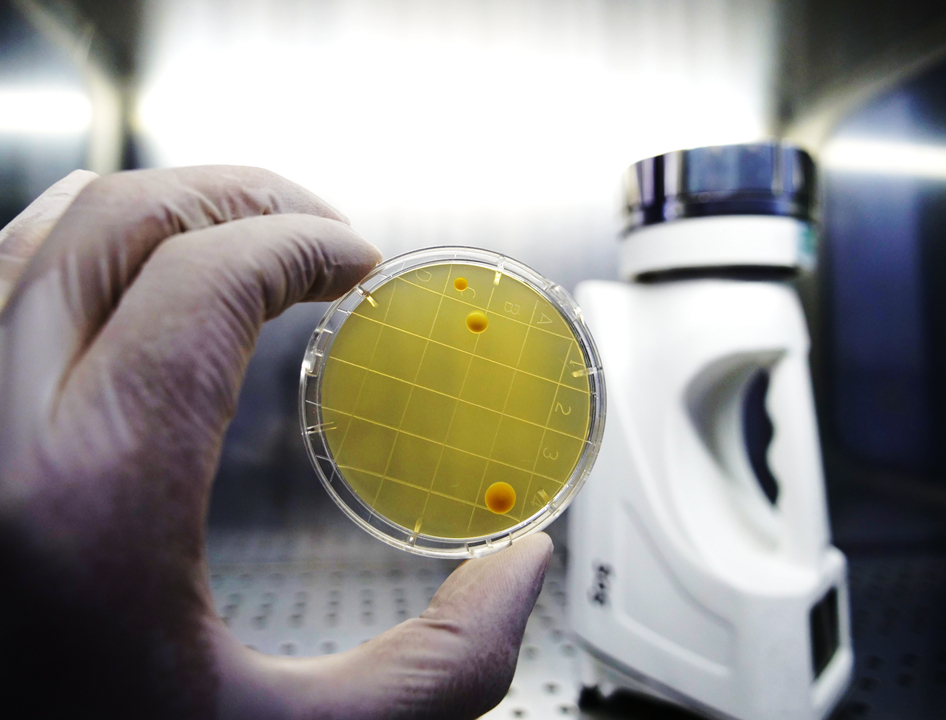

Dove la qualità incontra la sicurezza nel Biomedicale
Supportiamo le aziende del settore medicale, accompagnandole nel percorso di certificazione con soluzioni avanzate ed efficaci.


Laboratori efficienti per la realizzazione di test microbiologici, tossicologici, chimici, biologici e funzionali per la qualificazione dei dispositivi medici.
Per la realizzazione di test di sterilità e di challenge test microbiologici sono state allestite 3 camere bianche in classe ISO 7 / ISO 5.
Oltre 30 anni di esperienza a supporto delle aziende che richiedono la certificazione del sistema qualità, la marcatura CE per i dispositivi medici e i test di qualificazione per prodotti e processi critici.
Consulenza
Servizi di consulenza specializzati sono dedicati alla marcatura CE e alle Regulatory Affairs per tutte le classi di Dispositivi Medici.
Laboratorio
Analisi di laboratorio (chimico-microbiologici, biocompatibilità e misurazioni) per tutte le classi di Dispositivi Medici: I, IIa, IIb, III. La qualificazione dei dispositivi, al fine di soddisfare i requisiti delle normative applicabili, viene effettuata tramite prove di laboratorio specifiche secondo gli standard più recenti e pertinenti.
Consulenza
Servizi di consulenza specializzati sono dedicati alla marcatura CE e alle Regulatory Affairs per tutte le classi di Dispositivi Medici.
Laboratorio
Analisi di laboratorio (chimico-microbiologici, biocompatibilità e misurazioni) per tutte le classi di Dispositivi Medici: I, IIa, IIb, III. La qualificazione dei dispositivi, al fine di soddisfare i requisiti delle normative applicabili, viene effettuata tramite prove di laboratorio specifiche secondo gli standard più recenti e pertinenti.
Coronati Consulting è una società certificata ISO 9001 e ISO 13485 e accreditata ISO 17025
Offriamo servizi di consulenza per lo sviluppo o il mantenimento di Sistemi di Gestione per la Qualità in aziende operanti nel settore biomedicale, secondo le seguenti regole di sistema: ISO 9001 (generale), ISO 13485 (biomedicale), attività di consulenza per la marcatura CE di dispositivi medici e prove di laboratorio.
Servizi di laboratorio per tutte le classi di dispositivi medici I, IIa, IIb, III

Ultime news